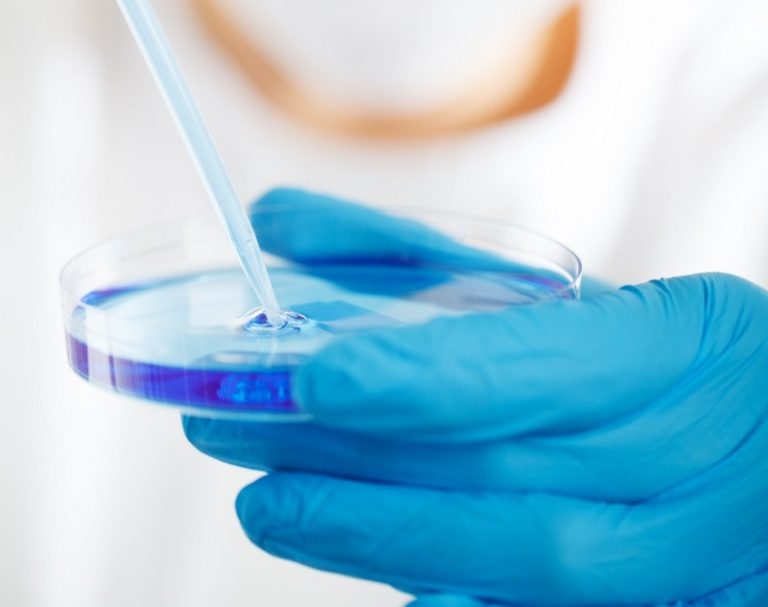

Justin Viktor
 Techno
Techno
Adatokalipszis: óriási biztonsági sérülékenység az Androidos mobilok kamerájában
Apokaliptikus méretű biztonsági sérülékenységet ismert be a Google, mely az Androidos készülékeket érinti. A potenciális támadók mindent rögzíthettek, ami eddig tudható: több százmillió Google és Samsung készülék érintett. Techno
Techno
Közeleg a Karácsony: kvantumszámítógép-piaci körkép
Nyakunkon az ünnepek és nekünk fogalmunk sincs róla, hogy nem csak a Google-nak van kvantum-számítógépe? Mivel felelőtlen vásárlónak az ördög a pénztárosa, következzen egy friss körkép a versenytársakról, és a kvantum-számítógépek piacáról. Bolygó
Bolygó
Ez a fenyegető, nem Greta Thunberg tekintete: Velencében tombol az aqua alta
Történelmi árvíz sújtja Velencét és ennek legalább részben az emberi mulasztás és az éghajlatváltozás az oka. A befejezetlen árvízgátló rendszer nem nyújtott megfelelő védelmet az emelkedő tengerszint ellen. TechnoMegérinthető animált hang-hologramok
Érdemes volt várni: már animált hang-hologramot is képesek vagyunk készíteni, amit meg is lehet érinteni. A három dimenziós "mozgó képhez" nincs szükség másra, mint egy apró polisztirol labdára és egy sor szintén parányi hangszóróra. Ember
Ember
A laborban növesztett emberi agyszövet talán öntudatánál van, és szenved
A Petri-csésze a tudományos laboratóriumok bölcsője, világszerte ott van az alapkészletben, benne a legkülönfélébb dolgok, általában baktérium- vagy vírustörzsek, különféle állati eredetű szövetek, melyek ismét csak általában: növekednek. Néha ezek emberi szövetek. Az is megesik, hogy emberi agyszövet növöget benne. Garázs
Garázs
Árammegosztás: saját autód lehet az új villamos erőmű
Van egy jó és egy rossz hírünk. A jó: a villamosenergia hálózat működéséhez szükséges energiatároló kapacitás hamarosan elérhetővé válik. A rossz: a saját elektromos autód akkumulátora lesz az. Tudás
Tudás
Száz(ezer)halombatta Japánban
Képzeljük el, hogy a régészek azonosítanak 160 000 darab feltáratlan halomsírt, melyek Szent István királyunk előtt 700 évvel élt magyar törzsfők és előkelők számára készültek. Majd ezt követően hozzájuk sem nyúlnak, mivel ezt törvény tiltja meg nekik. Nehéz ugye? Pedig Japánban ép ez történik. Techno
Techno
Blöff vagy forradalom: Fúziós reaktor az amerikai hadihajókon
Kompakt fúziós reaktort szabadalmaztatott az USA haditengerészete. Áttörést történt az amerikai energia dominanciában? Egyelőre nem világos, hogy ez a szabadalom valóban monumentális tudományos áttörést jelent-e. Néhányan azt állítják, hogy ez csupán egy dezinformációs művelet, egy kísérlet arra, hogy zsákutcába juttassák Amerika versenytársainak kutatásait. Ember
Ember
Google coming out: titokban milliónyi orvosi betegadatot gyűjtöttek
A Google beismerte a Csalogány Projekt létezését, miután megvádolták, hogy titokban személyes egészségügyi adatokat kezel a felhasználókról. A társaság azt állítja, hogy mindezt legálisan teszi. Techno
Techno
Kína önállóan gyilkoló drónokat árul (a Google-nak pedig rossz hete van)
Képzeljük el: gyilkos katonai robotok, melyek emberi jóváhagyás nélkül támadhatnak bármire. Techno
Techno
Lehet, hogy a jövőben ugyanúgy vehetünk áramot a telefonunkhoz, mint kávét a Starbucksban
10 teljes telefonfeltöltést valaki? Kérnék 22 Celsius fok meleget 7 napra! 24 lett, maradhat? A jövőben talán nem is lesz olyan szokatlan, ha úgy adjuk vesszük a szükséges energia vagy adatmennyiséget mint ma a zöldséget vagy ingóságainkat. De mikor is érkezik el ez a jövő pontosan? Ember
Ember
Szívbaj: a mesterséges intelligencia szól, ha hamarosan meghalunk
Egy mesterséges intelligencia algoritmus előre jelezheti ha az ember egy éven belül meghal a szívvizsgálati teszteredmények alapján - még akkor is, ha az orvosok nem találtak semmilyen problémát. Ez rejtély és egyelőre fogalmunk sincs, hogyan történik. Ember
Ember
Közelednek a halál utolsó órái
Az emberiség legnagyobb álma a halhatatlanság, nem csoda hát, hogy a történelem során számtalan formában kereste, kutatta a gyorsan amortizálódó emberi test megóvásának legkülönfélébb módjait, a halál előtt és után egyaránt. Bolygó
Bolygó
Én nem mondom, hogy klímaváltozás van, de...
Ma, 2019. november 11-én van az első nap az írott történelemben, hogy Ausztráliában nem esett egy csepp eső sem. Sehol. Odalent szárazság van, kontinensszerte lángol a bozót és pokoli a forróság. EmberEgyszerűen tabu: a halottak újraélesztése
A halál elleni küzdelem sok formában és területen zajlik. Néha igazán hosszú távon, mint a lefagyasztásos szolgáltatások esetében, néha képtelenül és elkeseredetten, mint a fejátültetés ötleténél, néha pedig olyan, az etika határait feszegető megoldásokkal, mint amiről ez a cikk is szól. ŰrFriss hírek az USA és Kína titkos kém-űrrepülőiről
Az amerikai légierő titokzatos kém űrrepülője, az X-37B, október végén visszatért a Földre, miután új rekordot felállítva, több mint két évet keringett a bolygó körül. Még nem ismeretes, hogy pontosan mi a jármű célja , de a Légierő annyit elismert, hogy az űrhajó számos apró műholdat vitt magával az űrbe a küldetés során. Bolygó
Bolygó








